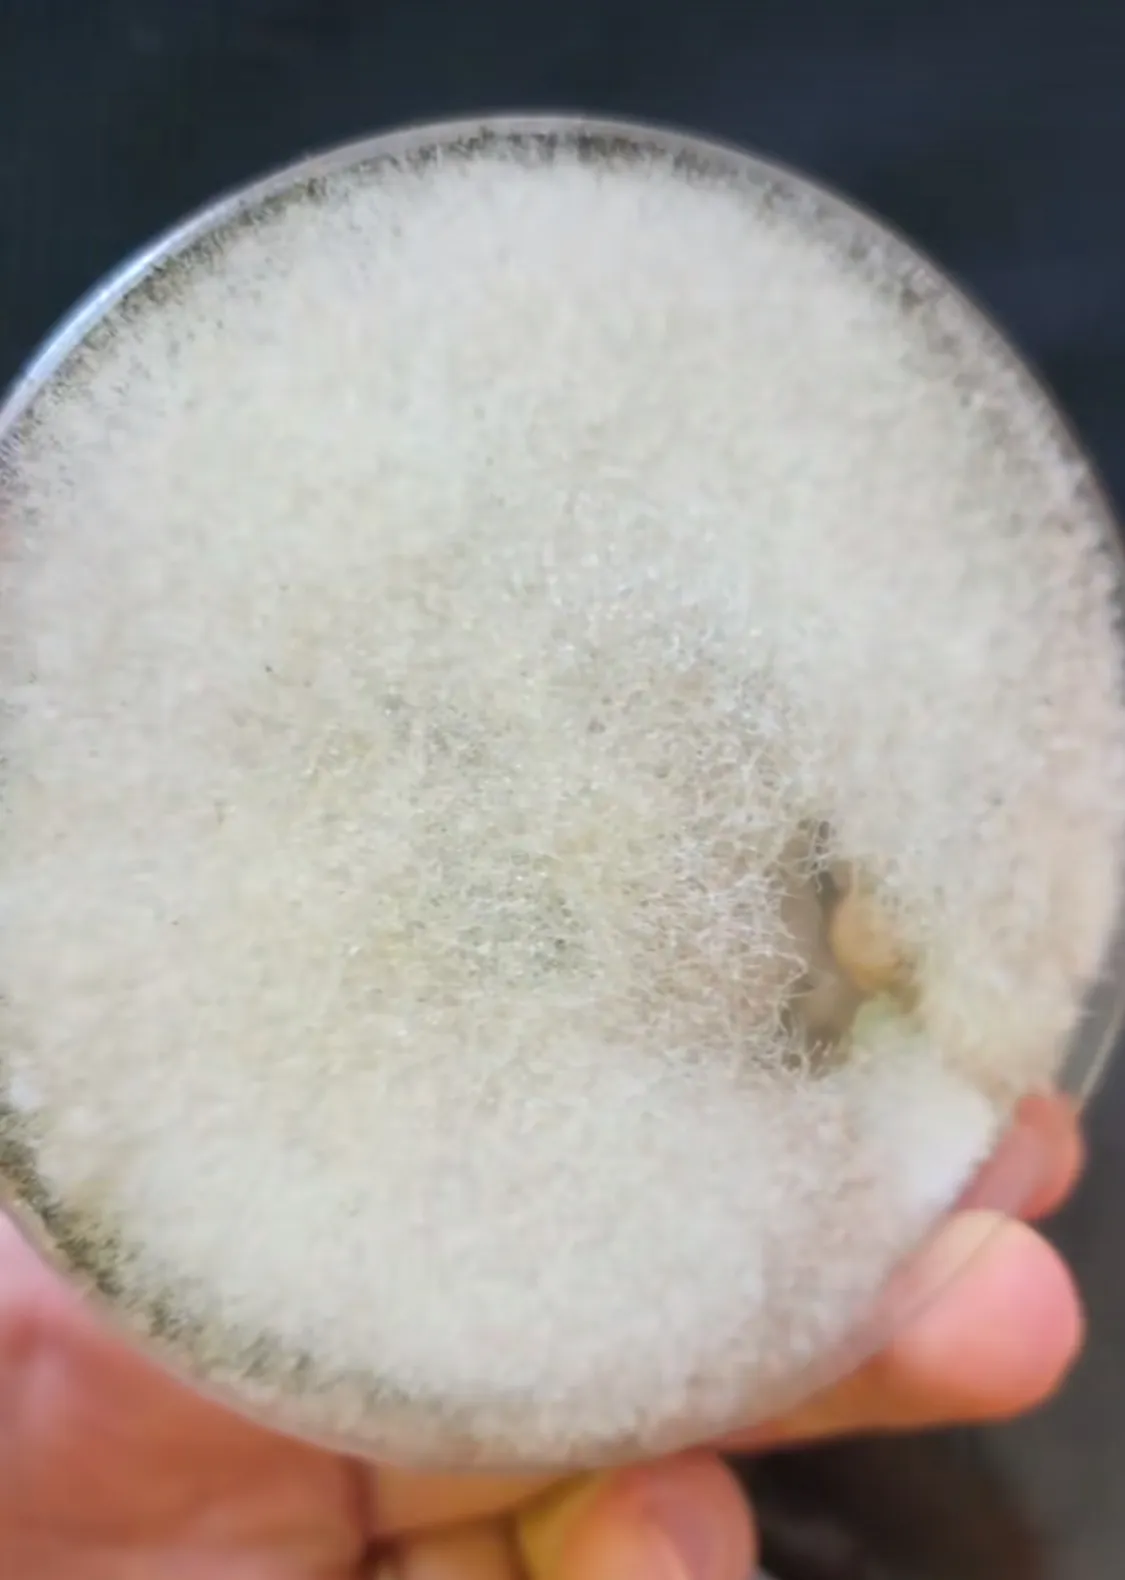
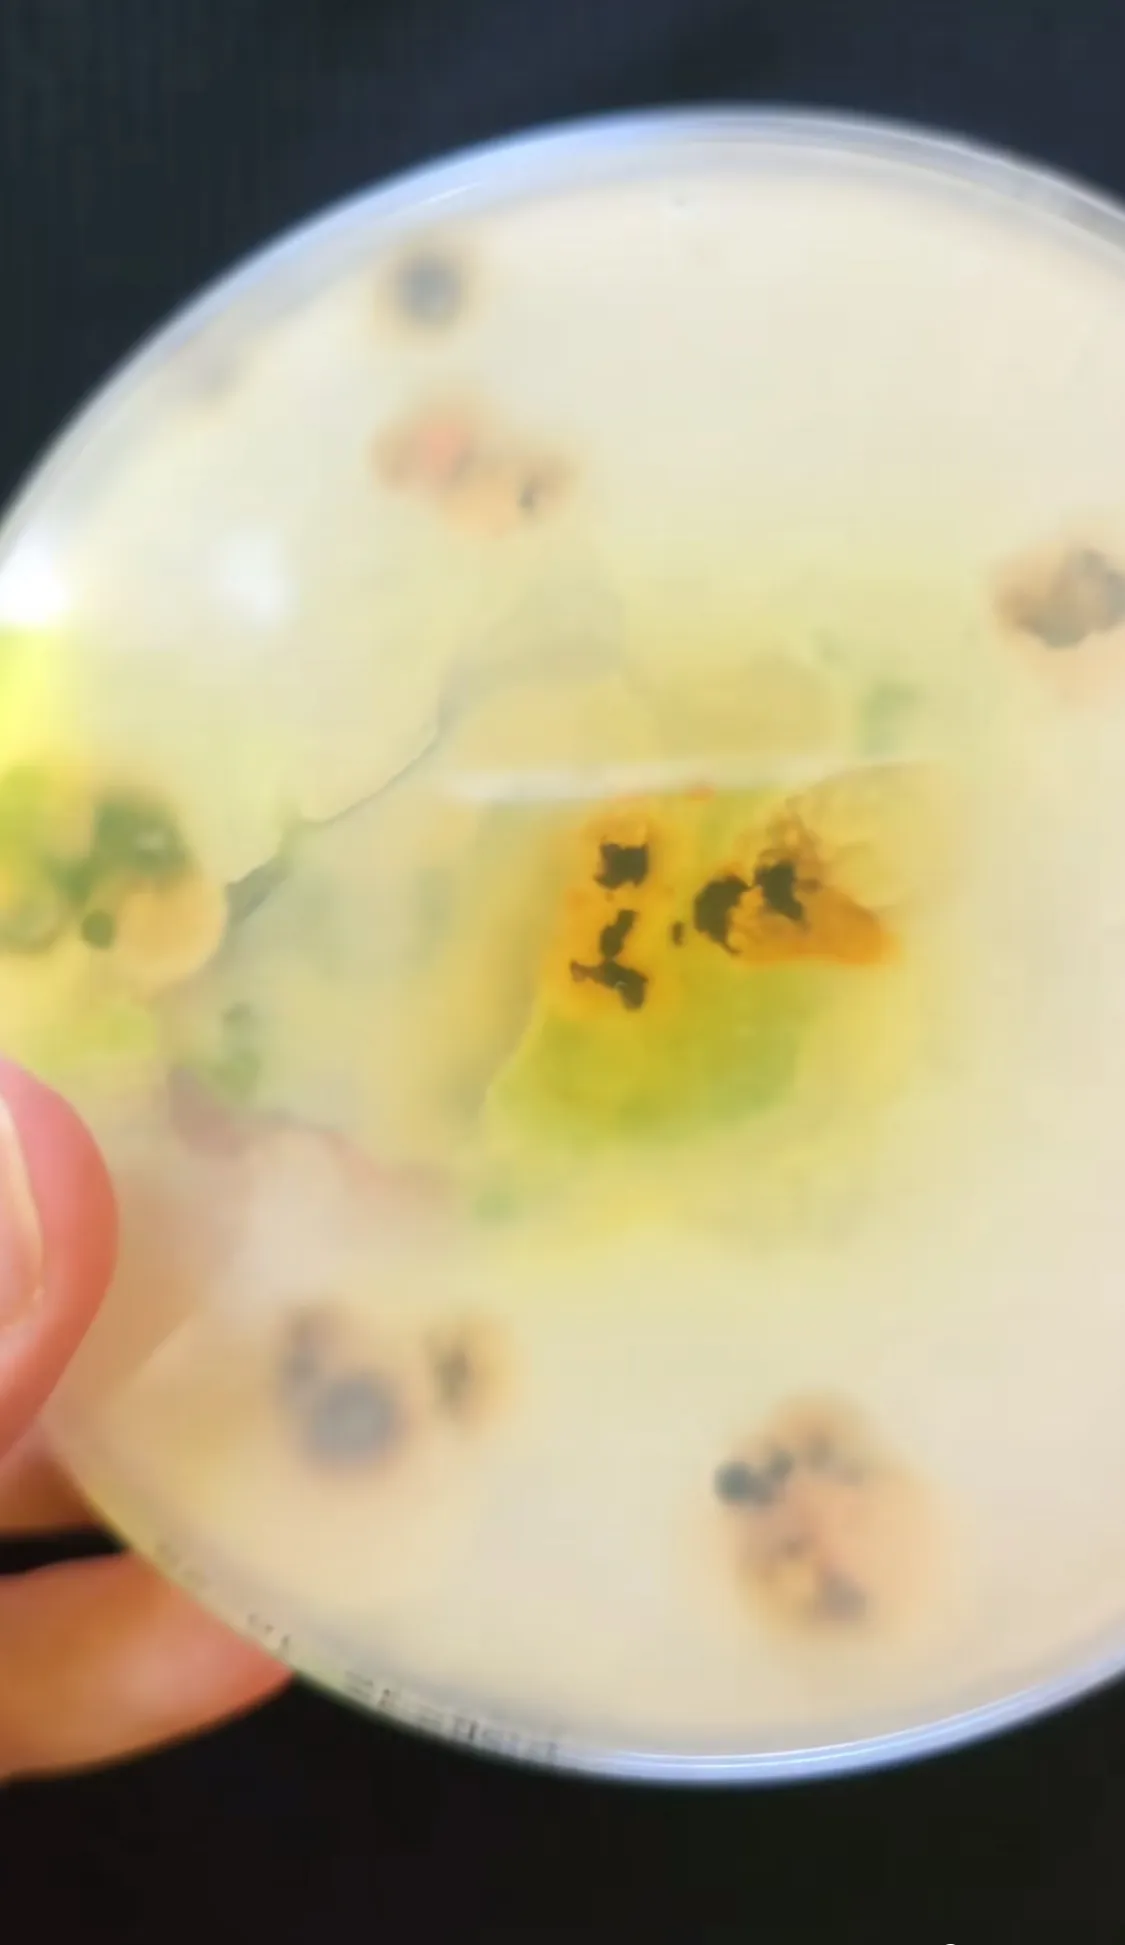

A klíma hatalmas segítség, hiszen nyáron lehűti, télen pedig felfűti az otthonunkat. Azonban, ha nem megfelelően tartjuk karban, akkor komoly légúti betegségeket is kaphatunk miatta. A TikTok kedvenc gázszerelője és növényorvosa most összefogott, hogy megmutassák, mit rejt egy klíma. amit évek óta nem takarítottak.

Rita, a növényorvos előszeretettel tesztel le szinte bármit, legyen az használati tárgy, vagy élelem, hogy bemutassa, milyen mikroorganizmusok élnek rajtuk. Dániel, a gázszerelő közérthetően magyarázza el és mutatja be például azt, hogyan kell bekapcsolni egy konvektort, miként kell a legegyszerűbben megjavítani a vécétartályt, vagy a csöpögő csapot; de képes hűtőből klímát varázsolni is. Most Gyuris Rita növényorvossal dolgozott együtt. Mintát vett egy hét éve nem tisztított klímából, majd postán elküldte Ritának.

A növényorvos örömmel vágott neki a feladatnak és szemléltette, hogy miért érdemes évente tisztítani a klímákat. A minta mellett egy kacsa figurát is kapott.
Borítékban volt a kis csomagminta és egy ajándék kis kacsa, ami nagyon cuki
– mondta Rita, aki hozott anyagból dolgozott. A zacskóból mintavevő pálcával vette ki a porszerű anyagot, amit speciális táptalajra, úgynevezett agar lemezre helyezte a mintát, hogy felszaporodhassanak a különböző baktériumok és gombák.
Csak egyszerűen ráhelyeztem az agar lemeznek a tetejére, illetve a pálcát is belenyomkodtam különböző pontokra, hogy még több minden nőhessen fel róla.
Nem csak gombatelep, meg gombák, hanem baktériumok is növekedtek rajta, ami a gombatelep alatt van, tehát látszik, hogy ott is nőttek, ahová hozzáérintettem a pálcát.
„Nem véletlenül mondják, hogy a klímát minden évben alaposan ki kell takarítani” - zárta Gyuris Rita.
Portfóliónk minőségi tartalmat jelent minden olvasó számára. Egyedülálló elérést, országos lefedettséget és változatos megjelenési lehetőséget biztosít. Folyamatosan keressük az új irányokat és fejlődési lehetőségeket. Ez jövőnk záloga.